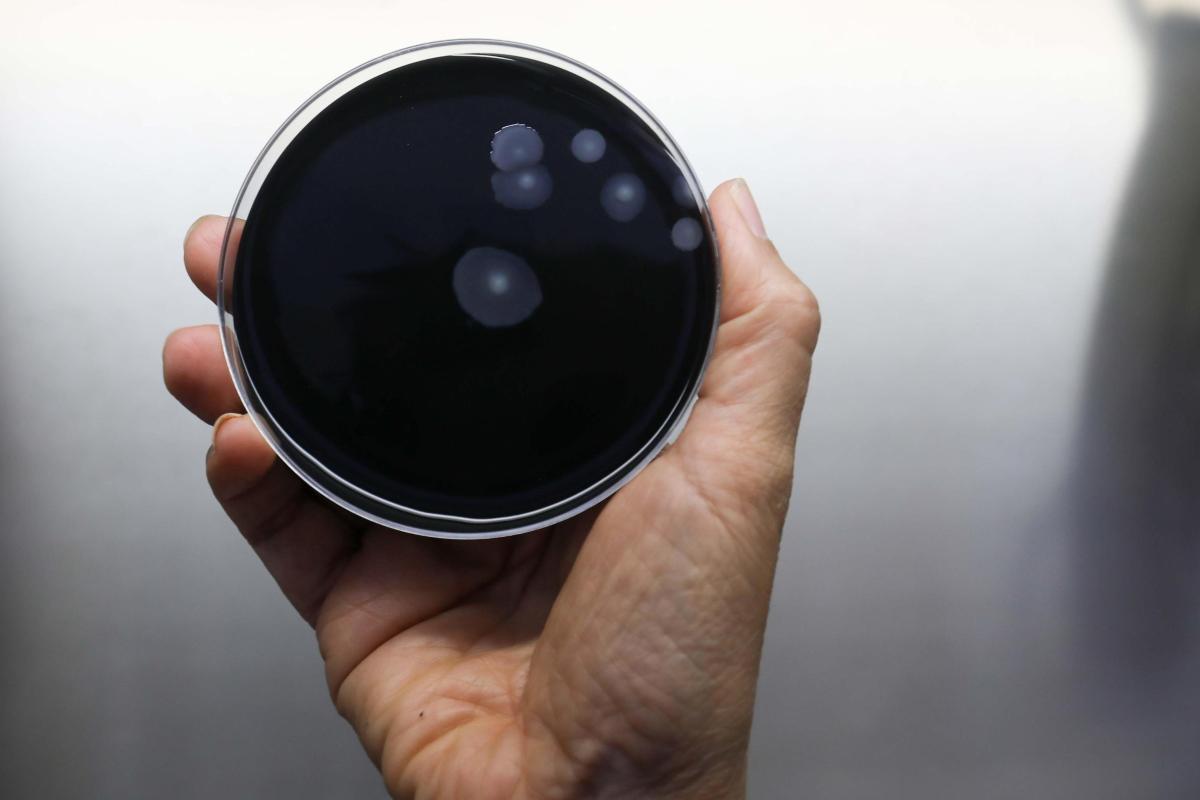
I batteri della legionella

La legionella a Milano continua a fare paura. Il contagio è in continua espansione nel quartiere di San Siro e l’ATS ha individuato le vie dove ci sono stati i casi
A Milano cresce la paura per la legionella. Attualmente i casi ufficiali sono 11 di cui 8 ricoverati in ospedale e una vittima. Ma si teme che il numero possa aumentare con forza nel corso nelle prossime ore visto che, almeno fino ad oggi, non è stato individuato il focolaio. La certezza è rappresentata dal fatto che i contagi sono avvenuti in edifici vicini fra loro e nel quartiere di San Siro. Per il resto non si hanno particolari informazioni.
La speranza è che si possa riuscire in davvero poco tempo individuare e fermare il focolaio. In attesa che il lavoro da parte dei sanitari si completi, il consiglio è quello di rivolgersi al proprio medico in caso di sintomi ed eventualmente recarsi in ospedale. Ricordiamo che il contagio può diffondersi dalla rete idrica.
Milano, legionella a San Siro: la mappa dei contagi
Al momento i contagi sono avvenuti principalmente nel quartiere di San Siro ad una distanza di circa 500 metri. Quindi l’area è quella compresa fra le vie Capecelatro, Tracia, Preneste, Rembrandt e Morgantini, le case popolari di Aler e non solo. Sono in corso comunque tutti gli approfondimenti del caso per capire eventuali altri luoghi sensibili e magari un collegamento fra le persone che hanno avuto un contagio.
LEGGI ANCHE >>> Allarme legionella in alcune zone di Milano: c’è un morto e diversi ricoverati
Per il momento non sembrano esserci assolutamente contatti diretti fra le parti e questo sembra rappresentare una conferma di come il virus sia nell’acqua. Ad oggi, però, il focolaio non è stato trovato e, di conseguenza, le indagini delle autorità locali proseguono con la necessità di individuare luogo.

Un passaggio per mettere fine al contagio e isolare il virus. Per adesso la cosa da fare è quella di prestare la massima attenzione e contattare il medico in caso di sintomi. La speranza è che tutto possa trascorrere in davvero poco tempo, ma ad oggi c’è una situazione di allarme nel quartiere di San Siro.
Il contagio e come prevenire la legionella
Come precisato in precedenza, il contagio della legionella arriva solamente tramite la rete idrica di quella zona e attraverso l’inalazione di minuscole gocce di acqua contaminata. Non è possibile che il virus si trasmetti da persona a persona. Il consiglio pre pervenire qualsiasi forma di malattia è fare la doccia dopo aver fatto scorrere l’acqua per alcuni minuti oppure in cucina utilizzare quella calda sopra i 50 gradi.




